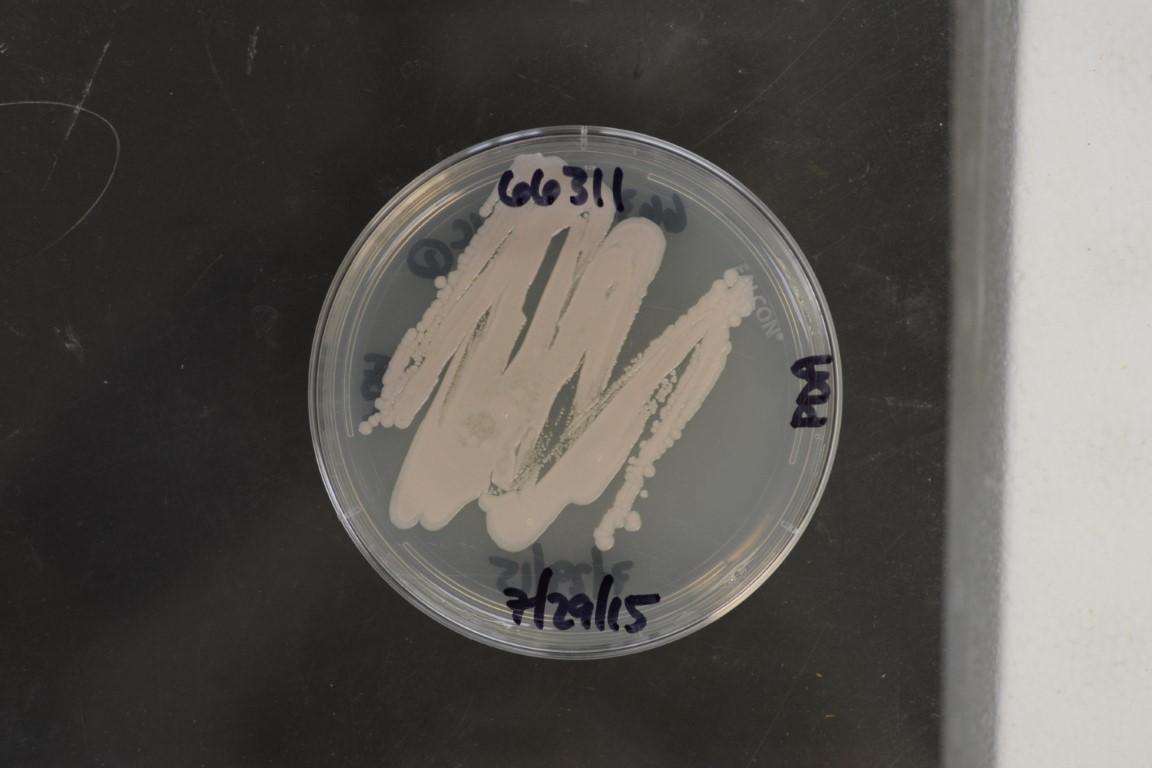

Jaminaea sp
NRRL 66311(Type Strain)
Accession numbers in other collections:MCA5214
Source:Teeratas Kijpornyongpan
Isolated from(substrate):air sample
Substrate location:Private Garden in Coral Gables,Florida,USA
Growth media:Potato Dextrose Agar(number 3)
Optimum growth temperature:25C
Strain images:
NRRL_66311_3.jpg

Comments:creamy pink colony;unique ITS sequence
NRRL66311